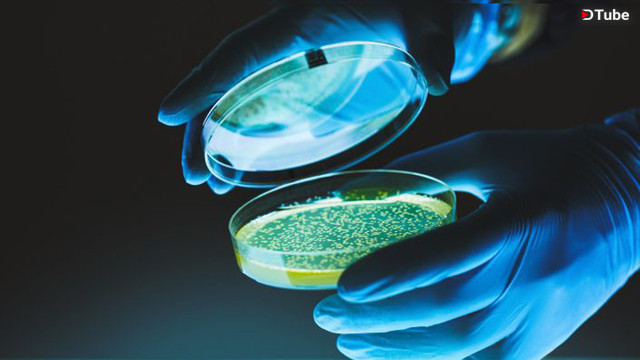

💟==--Download the App and ENTER TO WIN 20-FREE 🔑BitcoinRich.com Subscriptions!! Limited Time.. Rules are download app TimiPatient and leave review to Win!!! Announcement on Monday 11/19/18.
⭐⭐⭐⭐⭐Apple IOS: https://itunes.apple.com/us/app/timipatient/id1439247799?mt=8
⭐⭐⭐⭐⭐Android: https://play.google.com/store/apps/details?id=io.timicoin.timipatient&hl=en_US
💖Learn more about TimiHealth: https://www.amtvmedia.com/timi-health/
✍️Wheres Your DNA? Sign the Petition! https://www.amtvmedia.com/timi-dna/
*Download the TimiPatient apps: https://www.TIMIDNA.com
Twitter: https://twitter.com/amtvmedia
Facebook: https://www.facebook.com/amtvmedia
▶️ DTube
▶️ IPFS
Warning! This user is on my black list, likely as a known plagiarist, spammer or ID thief. Please be cautious with this post!
If you believe this is an error, please chat with us in the #cheetah-appeals channel in our discord.